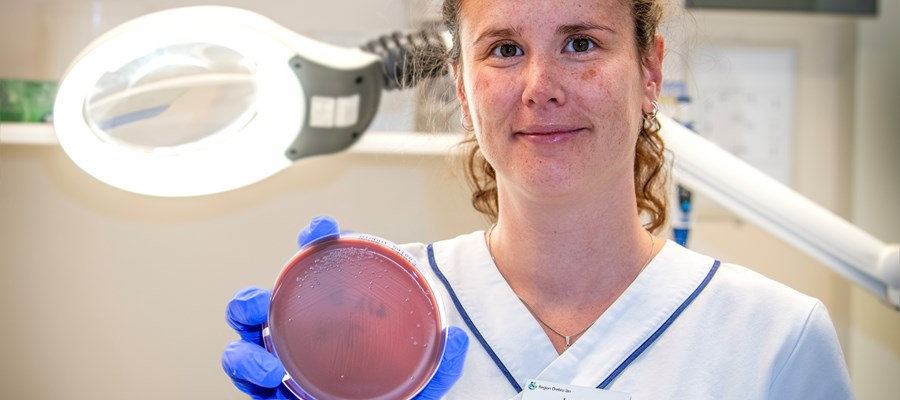
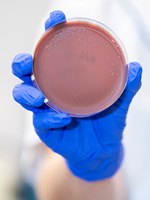

den 23 augusti 2024
Ny forskning ökar förståelsen för farlig bakterie
Bakterien Neisseria meningitidis kan vara helt ofarlig och vissa bär den i sina övre luftvägar. Men ibland kan bakterien orsaka invasiv sjukdom i form av sepsis, tidigare kallad blodförgiftning, och hjärnhinneinflammation. I sin forskning vill biomedicinska analytikern Lorraine Eriksson förstå varför.

Lorraine Eriksson
Forskare. Foto: Maria Bergman / Region Örebro län.
Bakterien Neisseria meningitidis.
Foto Maria Bergman/ Region Örebro län.
För att få en ökad förståelse om vad som kan ligga bakom utvecklandet av sjukdom vill Lorraine Eriksson i sin forskning undersöka meningokock bakterier.
– Vi vet att meningokocker kan orsaka allvarliga sjukdomar och är livshotande om inte behandling ges i tid. Genom att undersöka bakterien hoppas vi på att hitta markörer som kan avgöra om det finns risk att bakterien kommer att orsaka sjukdom, säger Lorraine Eriksson, biomedicinsk analytiker inom verksamhetsområde laboratoriemedicin på Universitetssjukhuset Örebro och tidigare doktorand på Örebro universitet.
Sepsis och hjärnhinneinflammation är två sjukdomar som snabbt behöver behandlas. Tiden från att man blir smittad tills man blir sjuk brukar vara två till tre dagar. När man blir sjuk kan man få flera symptom som feber, svår huvudvärk, kräkningar och illamående. Meningokockinfektion behandlas med antibiotika.
Orsaken är genetiska skillnader
För att förstå vad som leder till sepsis och hjärnhinneinflammation har bakteriens arvsmassa undersökts för att försöka hitta genetiska skillnader mellan bakterier som har orsakat sjukdom samt de som hittats hos friska bärare.
– Vi har även undersökt om det finns några observerbara skillnader mellan bakterierna. Dessa studier gav oss vissa svar på vad hos bakterien som kan påverka övergången från bärarskap till sjukdom, förklarar Lorraine Eriksson.
– Våra resultat visar att det dels finns genetiska skillnader inom olika grupper av bakterien som kan leda till sjukdom. Men även att det finns små genetiska variationer inom gener som skiljer mellan meningokocker som orsakar invasiv sjukdom och dem som hittas hos bärare, säger hon.
Men det är inte alltid så enkelt. Även två genetiskt lika meningokocker kan orsaka att en patient blir sjuk medan en annan person bara bär på den utan att bli sjuk. Det visar att det finns fler faktorer som avgör om en person blir sjuk eller inte.
– Det kan då vara att det finns små genetiska skillnader inom generna som kodar för olika varianter av samma protein – vilka skulle kunna ha olika roller i utvecklandet av sjukdom. Det som vi inte har tittat på än men som säkert spelar stor roll är även genetiska skillnader hos människor, vissa kan ha en ökad risk att utveckla invasiva sjukdomar. Dessa områden vill jag forska vidare inom, avslutar Lorraine Eriksson.
Källa: Universitetssjukhuset Örebro.